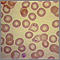

RPR test
Rapid plasma reagin test; Syphilis screening test
RPR (rapid plasma reagin) is a screening test for syphilis. It measures substances (proteins) called antibodies that are present in the blood of people who may have the disease.
How the Test is Performed
How to Prepare for the Test
No special preparation is usually needed.
How the Test will Feel
When the needle is inserted to draw blood, some people feel moderate pain. Others feel only a prick or stinging. Afterward, there may be some throbbing or slight bruising. This soon goes away.
Why the Test is Performed
The RPR test can be used to screen for syphilis. It is used to screen people who have symptoms of sexually transmitted infections or certain other symptoms. It is routinely used to screen pregnant women for the disease.
The test is also used to monitor the progress of the treatment for syphilis. After treatment with antibiotics, the levels of syphilis antibodies should fall. Unchanged or rising levels can mean a persistent infection.
The test is similar to the venereal disease research laboratory (VDRL) test.
Normal Results
A negative test result is considered normal. However, the body does not always produce antibodies specifically in response to the syphilis bacteria, so the test is not always accurate. False negatives may occur in people with early- and late-stage syphilis. More testing may be needed to check for syphilis.
What Abnormal Results Mean
A confirmed positive test result may mean that you have syphilis. If the screening test is positive, the next step is to confirm the diagnosis with a more specific test for syphilis, such as the FTA-ABS test. The FTA-ABS test will help distinguish between syphilis and other infections or conditions.
How well the RPR test can detect syphilis depends on the stage of the infection. The test is most sensitive (almost 100%) during the middle (secondary and latent) stages of syphilis. It is less sensitive during the early (primary) and late (tertiary) stages of the infection.
Some conditions may cause a false-positive RPR test, including:
- Hepatitis C
- HIV/AIDS
- Lyme disease
- Certain types of pneumonia
- Malaria
- Systemic lupus erythematosus and some other autoimmune disorders
Risks
There is little risk involved with having your blood taken. Veins and arteries vary in size from one person to another and from one side of the body to the other. Taking blood from some people may be more difficult than from others.
Other risks associated with having blood drawn are slight, but may include:
- Excessive bleeding
- Fainting or feeling lightheaded
- Multiple punctures to locate veins
- Hematoma (blood accumulating under the skin)
- Infection (a slight risk any time the skin is broken)
References
Radolf JD, Salazar JC. Syphilis (Treponema pallidum). In: Blaser MJ, Cohen JI, Holland SM, et al, eds. Mandell, Douglas, and Bennett's Principles and Practice of Infectious Diseases. 10th ed. Philadelphia, PA: Elsevier; 2026:chap 243.
US Preventive Services Task Force; Mangione CM, Barry MJ, et al. Screening for syphilis infection in nonpregnant adolescents and adults: US Preventive Services Task Force Reaffirmation Recommendation Statement. JAMA. 2022;328(12):1243-1249. PMID: 36166020 pubmed.ncbi.nlm.nih.gov/36166020/.
Review Date: 8/5/2025
Reviewed By: Jatin M. Vyas, MD, PhD, Roy and Diana Vagelos Professor in Medicine, Columbia University Vagelos College of Physicians and Surgeons, Division of Infectious Diseases, Department of Medicine, New York, NY. Also reviewed by David C. Dugdale, MD, Medical Director, Brenda Conaway, Editorial Director, and the A.D.A.M. Editorial team.
© 1997- A.D.A.M., a business unit of Ebix, Inc. Any duplication or distribution of the information contained herein is strictly prohibited.